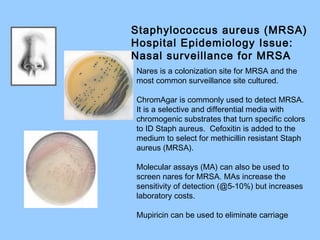
Nares is a colonization site for MRSA and the
most common surveillance site cultured.
ChromAgar is commonly used to detect MRSA.
It is a selective and differential media with
chromogenic substrates that turn specific colors
to ID Staph aureus. Cefoxitin is added to the
medium to select for methicillin resistant Staph
aureus (MRSA).
Molecular assays (MA) can also be used to
screen nares for MRSA. MAs increase the
sensitivity of detection (@5-10%) but increases
laboratory costs.
Mupiricin can be used to eliminate carriage
Staphylococcus aureus (MRSA)
Hospital Epidemiology Issue:
Nasal surveillance for MRSA
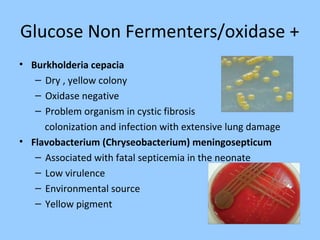
Glucose Non Fermenters/oxidase +
• Burkholderia cepacia
– Dry , yellow colony
– Oxidase negative
– Problem organism in cystic fibrosis
colonization and infection with extensive lung damage
• Flavobacterium (Chryseobacterium) meningosepticum
– Associated with fatal septicemia in the neonate
– Low virulence
– Environmental source
– Yellow pigment
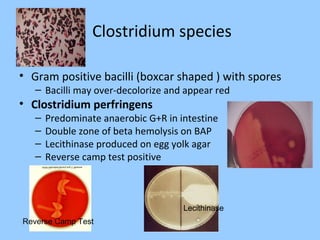
Clostridium species
• Gram positive bacilli (boxcar shaped ) with spores
– Bacilli may over-decolorize and appear red
• Clostridium perfringens
– Predominate anaerobic G+R in intestine
– Double zone of beta hemolysis on BAP
– Lecithinase produced on egg yolk agar
– Reverse camp test positive
Lecithinase
Reverse Camp Test

This document provides an overview of bacteriology concepts including definitions of aerobic and anaerobic bacteria. It discusses specimen collection and transport for aerobic bacteriology as well as the Gram stain procedure. Common aerobic agar media and identification of Gram positive cocci such as Staphylococcus, Streptococcus, and Enterococcus are summarized. Key details are provided about pathogenic species and their associated diseases.












![Rabbit plasma inoculated with organism
Incubate at 35˚C
Read at 4 hours and if negative read again at 24 hours
Negative tube coagulase =no clot
Coagulase negative Staph
Positive tube coagulase [at 4 or 24 hrs] =
Clot = Staph aureus
Tube Coagulase Reaction](https://image.slidesharecdn.com/websitebacteriology-150216235833-conversion-gate01/85/Bacteriology-13-320.jpg)

![Streptococcus pyogenes
• Genus/species for Group A beta Streptococcus [GAS]
Biochemical identification:
– Bacitracin KB sensitivity test – inhibited, no growth @ disk
– This test is not specific for Group A , it x-reacts with group C
– “A” disk is the Bacitracin disk
– PYR (pyrrolidonyl arylmidase) reaction
• Organism spotted on moist disk
• 2 min – RT incubation
• Add Cinnamaldehyde reagent
• Look for color reaction
• Pink = positive = Strep pyogenes
• This test is not exclusive for Strep pyogenes – Enterococcus and
Staph lugdunensis are also positive for PYR
– Therapy : Penicillin or Cephalosporin antibiotics](https://image.slidesharecdn.com/websitebacteriology-150216235833-conversion-gate01/85/Bacteriology-23-320.jpg)




![Strep agalactiae [GBS]
• Pathogen of the elderly – mostly bacteremia and urinary tract infection
• Pathogen of neonate – in utero or perinatal organism acquisition during
birthing process
– Early onset – within 7 days
– Late 7 – 28 days from birth process.
• Treatment: Penicillin or Cephalosporin (3rd
generation)
• Pregnant women carry organism in the cervix and/or rectal area. All
pregnant should be tested at 35 – 37 weeks of pregnancy.
– Enrichment methods for GBS is standard of practice and must be used
• Swab placed into LIM broth – incubate for 18 hours at 35 ˚C then
subculture onto Blood agar. This broth can also be used as an enrichment
method to enrich for molecular testing.
• Carrot enrichment broth turns orange with growth of group B Strep
Carrot Broth](https://image.slidesharecdn.com/websitebacteriology-150216235833-conversion-gate01/85/Bacteriology-28-320.jpg)












![Neisseria gonorrhoeae
– Acute urethritis, endocervix, ocular, rectal, oropharynx,
septic arthritis
– 10 – 20 % female ascend to PID but only 0.5% disseminate
– Gram stain of urethral discharge useful for male diagnosis,
however, cervix Gram stain not specific for females
– Transport for culture – charcoal swabs, No refrigeration
– Media: Selective Thayer Martin or Martin Lewis agar
– Amplification methods [PCR] increase sensitivity of
detection and superior to culture
– Produces a beta lactamase enzyme and also Chromosomal
resistance : Therapy: Ceftriaxone + Azithromycin or Doxycycline to prevent
resistance](https://image.slidesharecdn.com/websitebacteriology-150216235833-conversion-gate01/85/Bacteriology-41-320.jpg)













![Enterics that Ferment Glucose
• Escherichia coli
– Major aerobic NF in intestine
– #1 cause of UTI [@80%]
– Bacteremia, neonatal meningitis
– Abdominal cavity infections
– Spot indole reaction = positive
– Green sheen produced on EMB agar
• Pathogen of diarrhea
– Traveler’s diarrhea - travel to developing countries
– Enterohemorrhagic E. coli [0157:H7 as well as other serotypes]
• Bloody diarrhea usually acquired from eating undercooked cow
meat from an infected cow
• HUS – hemolytic uremic syndrome [hemolytic anemia,
thrombocytopenia, and renal failure] particularly in children
• Does not ferment sorbitol – most other E. coli types ferment
Sorbitol
Green sheen on
EMB agar
Mucoid colony
Indole positive =
Robin’s egg blue](https://image.slidesharecdn.com/websitebacteriology-150216235833-conversion-gate01/85/Bacteriology-55-320.jpg)



![Glu/lac/suc
fermented
with gas
Glucose
fermented
only
Glucose
fermented
with H2S
No CHO
fermentation
Non fermenter
Triple Sugar Iron Agar – Detect fermentation of
glucose, lactose and/or Sucrose and the
production of hydrogen sulfide [H2S]
Fermentation= yellow
Gas = Disruption of the agar
H2S
No fermentation =
red](https://image.slidesharecdn.com/websitebacteriology-150216235833-conversion-gate01/85/Bacteriology-59-320.jpg)


![Salmonella species
• Salmonella spp.
– Diarrhea with +/- fever – polys in the stool
– Infection from food - Eggs, meats and contaminated
uncooked vegetables, must ingest large #’s of organisms to
make you ill (1,00,000 bacteria), stomach acid protective
– Does not ferment lactose/ produces Hydrogen sulfide
– Selective agars for growth: SS and Hektoen
– Identification based on biochemical reactions & serologic
typing
– Kaufman White serologic typing scheme
• O Somatic (cell wall) antigen – Salmonella group “B”
• H flagellar antigens – 2 phases [h1 & h2] aids in speciation
Salmonella
• Vi capsular antigen – Found in S. typhi only](https://image.slidesharecdn.com/websitebacteriology-150216235833-conversion-gate01/85/Bacteriology-62-320.jpg)
![Salmonella Shigella
Agar (SS agar)
Salmonella and Shigella are
colorless due to lactose not
being fermented
Hektoen agar –
Salmonella produces H2S [Hydrogen
sulfide] producing black colonies
Shigella – green colonies
Normal flora – orange colored due to
fermentation of lactose](https://image.slidesharecdn.com/websitebacteriology-150216235833-conversion-gate01/85/Bacteriology-63-320.jpg)

![Shigella
• Diarrhea, +/-vomiting, fluid loss, polys and blood in stool ,
tenesmus, usually treated, Quinolone therapy
• Human to human transmission /control with good hygeine
• Low #’s of organisms to make you ill [10 – 100 bacteria]
• Non motile and No H2S produced (differ from
Salmonella) – Green colonies on Hektoen
• Does not ferment lactose
• 4 species based on somatic antigen
– S. boydii Group C
– S. dysenteriae Group A
– S. flexneri Group B
– S. sonnei Group D](https://image.slidesharecdn.com/websitebacteriology-150216235833-conversion-gate01/85/Bacteriology-65-320.jpg)






![Glucose non-fermenter
Oxidase Positive
Pseudomonas aeruginosa
• Fluorescent & blue-green
pigment(pyocyanin)
• Grape-like odor
• Growth at 42˚C
– Ps fluorescens/putida – no growth at 42°C
• Major pathogen in cystic fibrosis
– Mucoid strains [polysaccharide capsule]
– in combination with Burkholderia cepacia
– can cause major lung damage
• Nosocomial pathogen –
associated with water & moisture
• Intrinsically resistant to many antibiotics](https://image.slidesharecdn.com/websitebacteriology-150216235833-conversion-gate01/85/Bacteriology-72-320.jpg)
![Haemophilus species
Haemophilus influenza
– Variety of infections
– Transmission – close contact secretions
– Polysaccharide “B” capsule = virluence factor
– Requires 2 nutritional factors for growth
• X = hemin
• V= NAD (nicotinamide adenine dinucleotide)
• Demonstrate by satellite phenomenon or X/V strips
– Small pleomorphic GNR / Grows on chocolate agar
– Will not grow on 5% sheep’s blood agar
– Requires high level C0₂ [5 – 8%] for growth
– Vaccine targets the H. influenza type B
– Resistance to Ampicillin by beta lactamase production [15-
20 %], Cefotaxime becomes the antibiotic of choice
+](https://image.slidesharecdn.com/websitebacteriology-150216235833-conversion-gate01/85/Bacteriology-74-320.jpg)







![Brucella species
• Disease – Fever of unknown origin, significant joint pain
• Small gram negative coccobacilli – slow and difficult to grow from blood
cultures – intracellular pathogen of the RES system
– Castaneda biphasic blood culture held for 21 days [old school]
– Current: Automated Blood culture systems with growth within 5 days
• Specimens: blood and bone marrow most profitable
– Granuloma formation in bone marrow
• Serology can be used for genera/species diagnosis
• Brucella species in clinical specimen related to animal
species the patient was exposed:
– B. abortus – ingestion of raw cow milk
– B. melitensis – ingestion raw goat milk, feta cheese
– B. suis – contact with pigs B. canis - contact with dogs
Granuloma in bone
marrow](https://image.slidesharecdn.com/websitebacteriology-150216235833-conversion-gate01/85/Bacteriology-82-320.jpg)


![Helicobacter pylori
• Small curved Gram negative bacilli
• Cause of acute gastritis…..gastric adenocarcinoma
• Human to human transmission/ fecal oral route
• H. Pylori, Rapidly!! And strongly urease positive – used for
detection directly from gastric biopsy tissue
• Difficult to grow in culture
• Stool antigen/diagnosis and test of cure ]
Serum antibody for exposure
• Treatment – Antibiotics and acid
suppression
Histologic exam of gastric
biopsy
Hematoxylin-eosin stain or
Warthin-Starry Silver stain](https://image.slidesharecdn.com/websitebacteriology-150216235833-conversion-gate01/85/Bacteriology-85-320.jpg)
![Legionella
Legionella pneumophila most common species [6 serotypes]
• Requires cysteine in culture medium for growth
• Buffered Charcoal Yeast Extract agar -colonies form in 3-5
days
• Will not show on Gram stain of specimens
• Use silver impregnation stains in tissue
• Pulmonary disease associated with water,
cooling towers, shower heads, stagnant water
• Urinary antigen test will detect L. pneumophila type I
infection only
• Treatment: Erythromycin (macrolide)
BCYE](https://image.slidesharecdn.com/websitebacteriology-150216235833-conversion-gate01/85/Bacteriology-86-320.jpg)
![Bacteria without cell walls
• Mycoplasma and Ureaplasma – have cell membranes only! Media and
transport contain sterols to protect the membrane
• Do not form discreet colonies on agar plates – must read plates under a
microscope to visualize organisms [up to 14 days of incubation]
• M. pneumoniae –
– community acquired pneumonia
– Serology and PCR for diagnosis
– Cold agglutinins produced
• Genital mycoplasmas
– M. hominis – fried egg colony, vaginitis, cervicitis, postpartum sepsis,
neonatal infections , pre rupture of membranes
– Ureaplasma urealyticum – rapid urea hydrolysis in broth, NGU &
upper genital tract infection, spontaneous abortion, neonatal
infections
Ureaplasma
Mycoplasma hominis](https://image.slidesharecdn.com/websitebacteriology-150216235833-conversion-gate01/85/Bacteriology-87-320.jpg)

![Clostridium
• C. septicum –
– Bacteremia or Gas Gangrene in patient with underlying
malignancy
• C. difficile –
– Normal Colonization in 5% adults and 70% healthy infants
– Disease = Antibiotic associated colitis,
pseudomembranous colitis due to toxin production
[Virulence Factor]
• Toxin A – enterotoxin causing fluid accumulation
• Toxin B – potent cell cytotoxin
• Binary toxin (Nap1) strain is unique and produces larger amount of
toxins A and B and is more virulence
– Diagnosis of infection:
• EIA methods [toxin A/B] are not sensitive and are discouraged
• PCR methods [toxin B] are more sensitive and for infection
• Culture – Cycloserine, Cefoxitin, Fructose Agar [CCFA]](https://image.slidesharecdn.com/websitebacteriology-150216235833-conversion-gate01/85/Bacteriology-103-320.jpg)



![Bacterial vaginosis
• Clue cells are diagnostic
• Mixed anaerobic/aerobic bacterial infection - the two most common
organisms in vaginosis are:
– Gardnerella vaginalis (aerobic gram variable rod) and Mobiluncus
(anaerobic curved gram negative rod)
– Human blood agar used to culture Gardnerella, it
is beta hemolytic and distinctive morphology
• Nugent score – gram stain scoring system to diagnose
bacterial vaginosis [BV]
– Healthy = Lactobacillus-like Gram positive rods
– Intermediate = mixed bacterial types
– BV = Gardnerella and Mobiluncus on smear
Clue Cell](https://image.slidesharecdn.com/websitebacteriology-150216235833-conversion-gate01/85/Bacteriology-107-320.jpg)